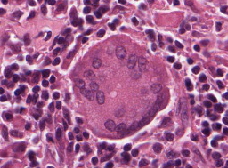

What binds to CD8 on the MHC I?
Alpha 3 subunit
What is this?

Caseating Granuloma
How can Th17 cells be involved in fungal defense?
They secrete IL-17 which can effect neutrophils to fight fungal infections
What is characteristic of Wiskott-Aldrich syndrome other than the WASP defect?
Failure to mount an IgM response. Triad (Pyogenic infections, eczema, and thrombocytopenia)
What are the two main moderators of pain in acute inflammation?
Bradykinin and PGE2
What is an important characteristic of LAD?
Recurrent bacterial infections that lack pus - because pus is fluid with dead neutrophils within
What are two diseases that present with Noncaseating granulomas?
Sarcoidosis and Crohns disease
What type of inflammation is necrosis associated with?
Acute inflammation
Why are CD25 polymorphisms associated with MS and Type I diabetes?
Treg cells are dependent on CD25 for survival, and polymorphisms in these can lead to ineffective signaling
Would a MPO deficiency yield a normal or abnormal NBT test?
It would yield a normal test because the MPO deficiency is downstream of what is actually being tested - thus the NBT test would appear normal
What is this?
A giant cell - characteristic of a granuloma
What is this?

Non caseating granuloma


What is CD27?
A plasma cell marker
What is the test for Rheumatoid factor?
This tests the levels of Ab directed at the Fc portion of IgG
What is the test of anti-CCP?
ELISA for antibodies against CCP
What is CD14?
The TLR on macrophages that binds to LPS on gram negative bacteria
What is Ulcerative Colitis?
Neutrophils within the crypts of the colon
What are the three ways mast cells can become activated?
Tissue trauma, IgE crosslinking, and Complement C3a and C5a
A FoxP3 mutation is known as what syndrome?
IPEX Syndrome
What is occurring in the light staining region of the thymus?
This is where DP T cells are being tested and selected for
Graves disease is characterized by what?
Activating auto abs to thyroid stimulating receptors. Hyperthyroidism.
What is the defining characteristic of microscopic polyangiitis?
Auto abs to myeloperoxidase
What is CD56?
An NK cell marker